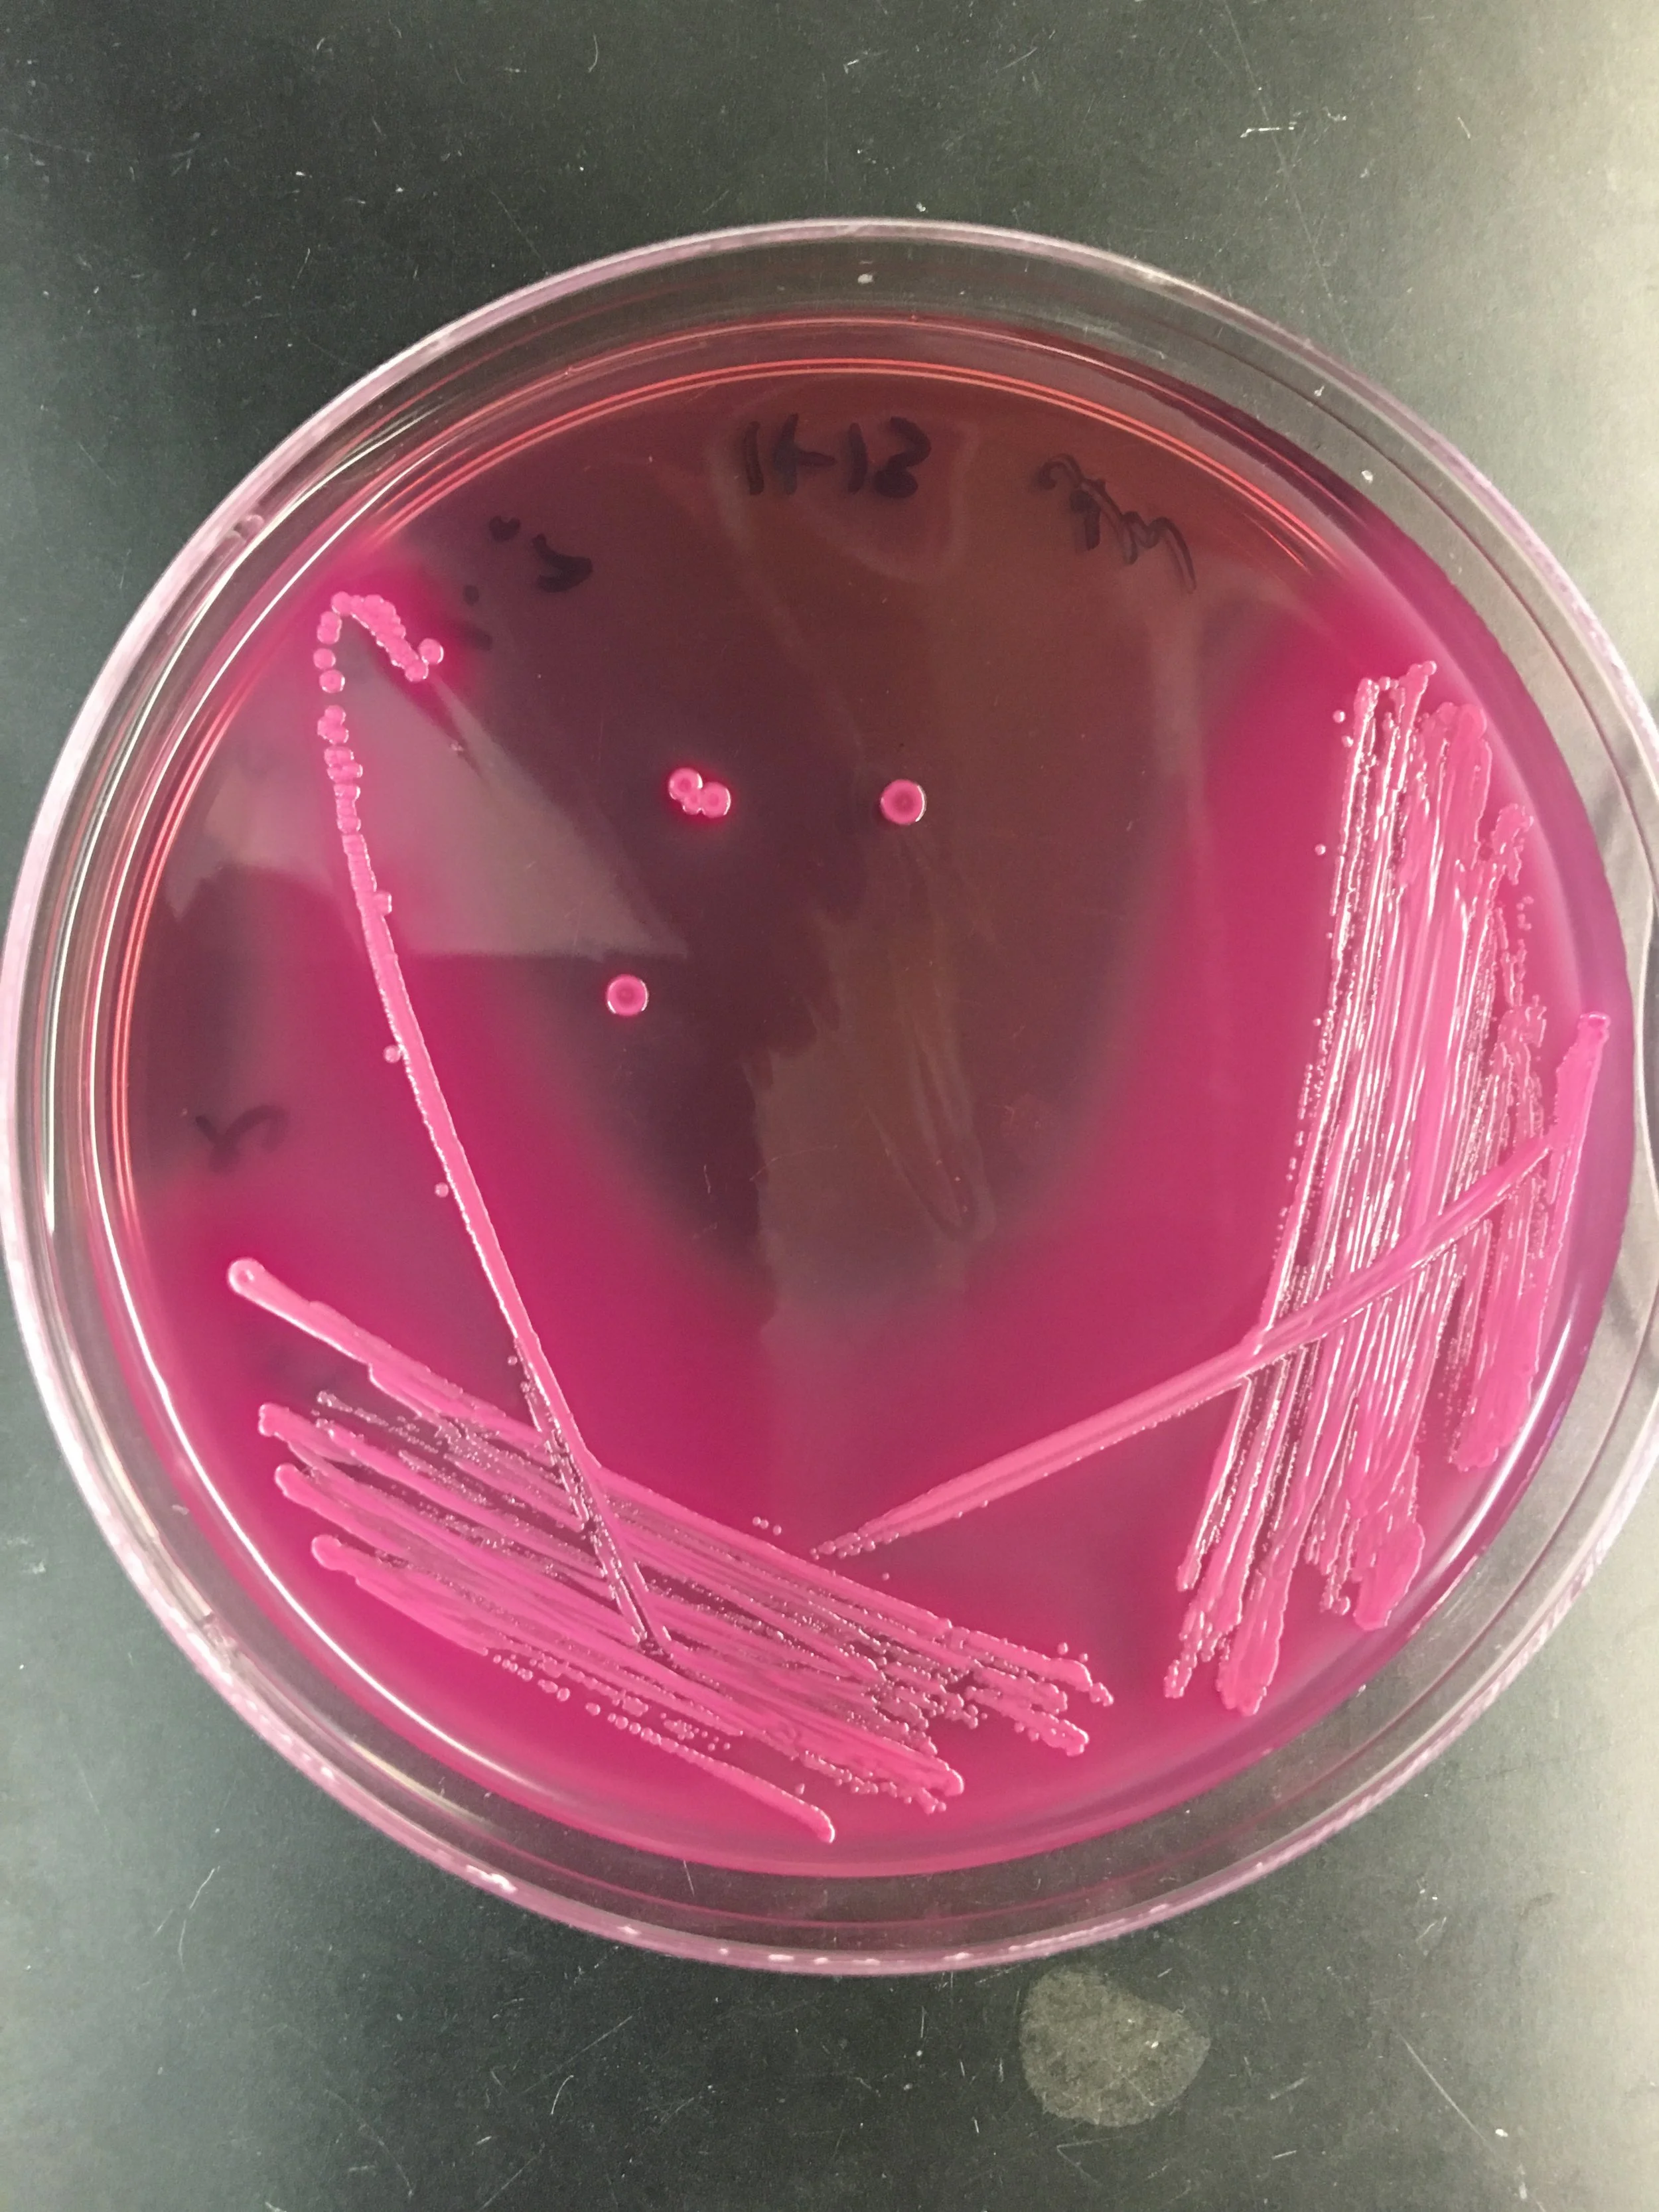

Research
How do gut bacteria influence immunity and cancer development?
How do gut bacteria influence immunity and cancer development?
Tumor Immunology

Bacterial Factors

Immunotherapy

Disease
Models
Bacterial Factors
Identify immunomodulatory factors of resident gut bacteria that protect against colon cancer
1) Bacterial surface structures are commonly detected by immune cells and are the major antigen associated with anti-bacterial signaling cascades. Our goal is to uncover novel biology and develop a pipeline for identifying bacterial surface structures and secreted products of interest that impact gut mucosal immunology, homeostatic balance of a healthy gut, and colon cancer development. Our work has shown that Bacteroides uniformis capsule molecules are immunomodulatory and lead to Natural Killer cell and T cell activation and anti-tumor effects. Currently we are investigating the mechanism behind capsule recognition and NK cell activation, and investigating Bacteroides uniformis secreted products.

2) We are also defining gut resident bacteria strain-level diversity and associated immunomodulatory phenotypes. We test strain level variations by 1) phenotypically assessing their immune modulation capabilities and 2) utilizing comparative genomics to identify genetic differences and uncover fundamental biology about B. uniformis and other gut commensals.
Tumor Immunology

Investigate how bacterial induced immune activation in the tumor microenvironment promotes anti-tumor immunity.
During my postdoc, I found that B. uniformis is protective against CRC progression in vivo using mouse models, in both an intestinal gut CRC model and in the transplantable subcutaneous model. This unique bacterial protection is dependent on NK cells. My lab is now systematically interrogating the NK cell pathways required for protection by defining mouse and human NK cell responses to B. uniformis in vitro and by using mouse models. Understanding the NK genes upregulated in the TME, induced by B. uniformis and other microbes, is critical for future translational applications such as identifying biomarkers and therapeutics.
Disease Models
Investigate how bacterial induced immune activation in the tumor microenvironment promotes anti-tumor immunity.
The Weis lab investigates human diseases using human samples and models that replicate diseases such as colon cancer and colitis.
normal
dysplasia
Immunotherapy
Determine mechanisms by which bacteria modulate immunotherapy responses and how we can harness as therapeutics.

I found that that the immune checkpoint inhibitor, a-CTLA-4, reduced tumor burden in murine CRC models with microbiotas from healthy humans, but was not effective with microbiotas from patients with CRC. When I supplemented animals bearing a CRC microbiota with B. uniformis and treated them with a-CTLA-4 immunotherapy in tandem, the mice were protected from tumorigenesis at levels greater than either treatment alone, suggesting a synergistic effect. This project investigates the molecular mechanisms behind this phenotype, and my lab is expanding this project to test multiple types of commensal bacteria in synergy with a-CTLA-4 and other immunotherapies. This project uses in vitro and in vivo approaches, using CRC mouse models and human samples (PBMCs, microbiota, and tumor tissue) with the goal of better directing personalized medicine.
